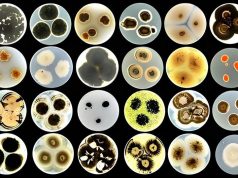
Табиғи материалдан жасалған жасанды синапс адам миының қызметін қайталайды

Жасанды интеллект (AI) технологияларын бизнеске енгізу – қарқынды дамып келе жатқан бағыттардың бірі. Digital Almaty-25 форумында Freedom Bank сарапшылары AI-ды жұмыс үдерістеріне енгізу, қауіпсіздікті күшейту және кибершабуылдардың алдын алу мен автосақтандыру саласындағы қолдану тәжірибесімен бөлісті.

AI және киберқауіпсіздік: жаңа мүмкіндіктер
Freedom Bank-те AI технологиялары жақында ғана қолданыла бастаса да, олар оң нәтижесін көрсетіп үлгерді. Freedom Holding Corp компаниясының бас техникалық директоры Ренат Тұқановтың айтуынша, халықтың көп бөлігі киберқауіпсіздік туралы жеткілікті ақпараттандырылмаған, ал кибершабуылдардан келген шығын орасан зор.

«Цифрлық әлемнің ауқымын қарастырайық: күн сайын 2,5 квинтиллион байт ақпарат өндіріледі. Оның ішінде құпия деректер де бар. Ал құпия ақпарат бар жерде оны заңсыз жолмен алуға тырысатындар да табылады. 2023 жылы кибершабуылдардан келген шығын 8 триллион долларды құрады», – деп пайымдайды Ренат Тұқанов.
Жасанды интеллект енгізілгеннен кейін жағдай өзгере бастады.
«AI күдікті әрекеттер мен аномалияларды алдын ала анықтап, проактивті мониторинг жүргізеді. Бұл жүйе өзін-өзі оқытып, үнемі жетілдіріліп отырады», – деп түсіндірді ол.
Фишингке қарсы күрес AI-дың тиімділігін көрсететін мысалдардың бірі. «Фишинг барлық кибершабуылдардың 83%-ын құрайды. Бірақ AI оны 90%-ға дейін төмендете алады», – дейді сарапшы.

Алайда киберқылмыскерлер де AI-ды өз мақсаттарына қолданатынын ескерген жөн. «Алаяқтар жасанды интеллектіні пайдалана отырып, жаңа тәсілдер ойлап табуда. Сондықтан бұл қауіпке дайын болуымыз керек», – деп атап өтті Ренат Тұқанов.
Freedom Bank және AI-комплаенс
Жасанды интеллект Freedom Bank-тің комплаенс жүйесіне де енгізілуде. Бұл туралы банктың бас комплаенс-бақылакшысы Әсел Сүлейменова тарқатып айтып берді.

Комплаенс- бақылаушы қандай қиындықтармен бетпе-бет келеді?
Алдымен санкциялық комплаенс мәселесін атап өтті. «Санкциялық тізімдер үнемі өзгеріп отырады, сондықтан клиенттік және серіктестік базаны үздіксіз тексеріп, заңға қайшы транзакцияларды болдырмау қажет», – дейді сарапшы. Сондай-ақ, санкцияларға байланысты экспорт-импорт келісімдері мен трансшекаралық аударымдарды бақылау маңызды.
Екінші маңызды бағыт – ақша жымқыру мен терроризмді қаржыландыруға қарсы күрес. «Бұрын қолма-қол ақша операциялары негізгі қауіп саналса, қазір қаражаттың басым бөлігі аударымдар арқылы шетелге шығарылады. Мұндай алаяқтық жүйелерін анықтау барған сайын қиындап барады», – дейді Әсел Сүлейменова.
Тағы бір мәселе – заңсыз криптовалюта биржалары мен құмар ойындар. «Бүгінде тіпті қаржылай сауатты адамдар да алаяқтардың құрбанына айналып жатыр. Ақша тікелей банк клиентінен алаяқтарға түспейді, олар дропперлер желісі арқылы өтеді де, криптовалюта биржаларында шешіледі», – деп түсіндірді сарапшы.
Банктың негізгі мақсаты – клиенттердің сенімін сақтау. «Комплаенс қағаз жүзінде ғана емес, нақты жұмыс істеуі керек», – дейді Әсел Сүлейменова.

Тағы қандай маңызды мәселелерге назар аудару қажет?
Асель Сүлейменова атап өткендей, клиенттің өзіне, оның байланыстарына және контрагенттеріне қатысты деректерді тексеру өте маңызды. Бұл процессте ақша көзінің заңдылығы, санкциялық тізімдерден шықпауы туралы ақпарат сұралады. Сонымен қатар, клиентттік операциясының экономикалық негізділігіне көз жеткізу қажет. Қазақстан Республикасының заңнамасы мен санкциялық талаптардың сақталуы да міндетті түрде тексеріледі.
«Банктік операцияларды жүзеге асыру барысында адам қанша маман мен қаншама дерек талданатынын тіпті білмейді», – деп қорытындылады Асель Сүлейменова.

Асель Сүлейменова жасанды интеллектіні қолданбайтын банктердің жиі кездесетін қиындықтары туралы өз ойымен бөлісті. Олардың қатарында ақпарат жинаудың қолмен жасалатын уақытты талап ететін процесі мен қателіктердің болуы, транзакциялық жүктемелердің артуы мен үлкен көлемдегі қолма-қол ақшасыз есеп айырысулар, клиенттермен тиімді байланыс орнатудың қиындығы, сондай-ақ санкциялық мәселелер мен үнемі өзгеріп тұратын реттеуші талаптардан туындайтын артық комплаенс талаптары бар.
Сонымен қатар, комплаенс саласындағы кәсіби мамандардың жетіспеушілігі де айта кетілді.
Ал Асель Сүлейменова пікірінше, банктерде AI комплаенс жүйесінің енгізілуі қызметкерлерге, әсіресе комплаенс-бақылаушыларға жүктелетін ауыртпалықты едәуір жеңілдетеді.
Айгүл Темірханқызы, Freedom Bank басқармасының төрағасы кеңесшісі, AI комплаенс жүйесін енгізу мен банк жүйесіндегі бақылауды автоматтандыру болашақта банктік сектордың дамуы үшін тиімді шешім екенін атап өтті.
Шешімі – AI Compliance жүйесі
Freedom Bank-тің басқарма төрағасының кеңесшісі Айнұр Темірханқызының айтуынша, AI Compliance – банк секторында автоматтандырудың болашағы.

Айгүл Темірханқызының айтуынша, AI комплаенс қолданудың көптеген артықшылықтары бар. Олардың бірі – үлкен дерекқорлармен үйлесімділік мүмкіндігі, бұл бастапқы және қосымша коммерциялық ресурстарды да қамтиды. AI комплаенс клиенттің цифрлық бейнесін қалыптастырып, тәуекелге бағытталған тәсілмен комплаенс шеңберін тарылтады. Сондай-ақ, AI комплаенс құжаттарды автоматты түрде тексеріп, сұрыптап, тілдік модельдер мен ақылды парсингті қолданады. Ол санкциялық реттеулерді тез арада жүйелендіріп, сандық талдау үшін дайын етеді. AI комплаенс клиентпен тікелей, ақылды чат-бот арқылы байланыс орнатуға мүмкіндік береді. Барлық деректерді талдап болған соң, AI комплаенс алдын ала шешім шығарады, осы шешімде комплаенс-бақылаушының назарын аудару қажет маңызды сәттерді белгілеу арқылы. Сондай-ақ, AI комплаенс клиенттің барлық өтінімдері бойынша жүйені біріктіреді және клиентке кері байланыс береді.

Айнур Темірханқызы атап өткеніндей, AI қолдану құжаттарды талдау процесін айтарлықтай жеңілдетеді: «AI-комплаенс келісімшарттарды 200 бетке дейін бірнеше минут ішінде өңдей алады, ішкі және сыртқы дереккөздерден, мысалы, Dow Jones, Spark сияқты ресурстардан алынған мәліметтерді талдай отырып, деректерді тиімді сараптайды».
Ол жақын арада AI комплаенс жүйесінің банктік жүйеде маңызды құралға айналатынына сенімді.
Дегенмен, Айгүл Темірханқызының пікірінше, банктер AI технологиясын қолданатын алаяқтарды да ескеруі керек, өйткені олар бақылау жүйелерін айналып өту және құжаттар мен қолтаңбаларды жасауда да осы технологияларды қолданады. «Банктерге күмәнді операцияларды тез анықтауға мүмкіндік беретін технологияларды енгізу маңызды» – деп түйіндеді ол.
Автокөлікті сақтандыру саласында AI қолдану
Автокөлікті сақтандыру саласында AI қолданудың маңыздылығы туралы Freedom Insurance басқармасының төрағасы Азамат Керімбаев сөз сөйледі.

Азамат Керімбаевтың айтуынша, цифрландыру процесіне кіріспес бұрын AI технологияларын қолданудың артықшылықтары мен кемшіліктерін мұқият саралап, жан-жақты талдау жүргізілген. «Біз біраз уақыт бойы міндетті автосақтандыру процесін цифрландыру қажеттігін ойластырдық», – деді спикер. Бұған дейін, көлік бағалауын мамандар жүргізген кезде, Қазақстанда сақтандыру төлемдерін алу уақыты 90 күнге дейін жетуі мүмкін еді.
«Біз дамудың осылайша жалғаса алмайтынын түсініп, төлемдер процесін толық цифрландырдық. Қазір барлық сақтандыру төлемдері тек онлайн жүзеге асырылады, ал орташа төлем мерзімі 5-10 күнге қысқарды», – деп нақтылады Азамат Керімбаев. Бұл көрсеткіш бәсекелестерімізден 9-16 есе жылдам.
Сонымен қатар, ол көптеген көлік фотосуреттерін талдағандарын айтты, олар апатқа дейінгі және кейінгі жағдайды көрсету үшін қолданылған. «Біз өзіміздің тәуелсіз тексеру процесін ойлап таптық. Бізде арнайы қызметкерлер немесе бағалаушы жоқ, барлық жұмыстарды бағдарлама атқарады», – деп бөлісті Азамат Керімбаев.
Бағдарлама әртүрлі бұрыштардан түсірілген фотосуреттер негізінде көліктің жағдайын, сызаттар мен шұңқырларды, тіпті кузовтың тазалығын тексереді. Содан кейін, бағдарлама ақауларға назар аудара отырып, көлік туралы егжей-тегжейлі сипаттама құрастырады.

Азамат Керімбаевтың пікірінше, заманауи технологиялардың қолдану мүмкіндіктері күн өткен сайын артып келеді. Олардың қатарында моделдеу, компьютерлік көру және жасанды интеллект элементтері де бар. Олардың енгізілуі тек уақыт мәселесі ғана.«Біз әлі толыққанды жасанды интеллектіні пайдаланамыз деп айта алмаймыз, бірақ бұл бағытта дамудың тоқтайтын түрі жоқ», – деді ол.
Маманның айтуынша, тәжірибе көрсеткендей, AI технологияларын енгізу компанияның бәсекеге қабілеттілігін айтарлықтай арттырды. Осы нәтижеге қол жеткізуге мемлекеттік дерекқорларға қосылу мүмкіндігі де маңызды рөл атқарған.
«Европалық хаттаманы енгізіп, сақтандыру тарихын және төлемдерді цифрландыру арқылы осы саладағы нарықтың 60%-ын иелендік», – деп қорытындылады Азамат Керімбаев.

AI технологияларының қолданылуы жыл сайын өсіп келеді. Соңғы деректерге сүйенсек, жасанды интеллекттің қолданылуы 63%-ға артқан. Алдағы 3-5 жыл ішінде AI өмірдің көптеген салаларына терең еніп, осы технологиямен жұмыс істеу дағдылары қазіргі адам үшін аса маңызды болмақ. Оны толық түсініп, оң өзгерістерге жету үшін компания қызметкерлері де ойлау жүйесін жаңартуы керек.
Freedom Bank мысалында, цифрлық революция мен AI технологияларын енгізудің нарыққа үлкен ықпал етуі мүмкін екеніне сенімді түрде айтуға болады.